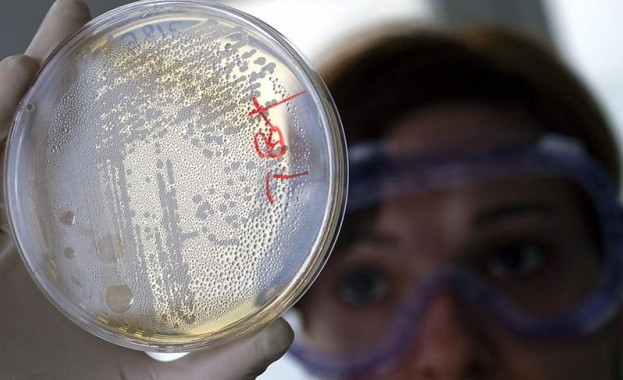
Разходите за научноизследователска дейност в България - почти три пъти по-ниски от средните за ЕС

-
 05 Юли 2026 |
05 Юли 2026 |
 USD / BGN 1.1448
USD / BGN 1.1448 GBP / BGN 0.8572
GBP / BGN 0.8572 CHF / BGN 0.9190
CHF / BGN 0.9190- Радиация: София 0.11 (µSv/h)
- Времето:
 София 0°C
София 0°C 
Разходите за научноизследователска дейност в България - почти три пъти по-ниски от средните за ЕС
15 Август 2014 | 12:59
/КРОСС/ Бюджетните разходи за научноизследователска и развойна дейност (НИРД) през 2013 г. възлизат на 200,4 млн. лв., като в сравнение с 2012 г. се увеличават с 1,3%, сочат данните на Националния статистически институт.
Делът на бюджетните разходи за НИРД от брутния вътрешен продукт също нараства - от 0,25% през 2012 г. на 0,26% през 2013 г., но все още е значително под средната стойност на този показател за ЕС-27 (0,70% през 2012 г.).
Структурата на бюджетните разходи за НИРД по социално-икономически цели през 2013 г. се променя незначително спрямо предходната 2012 година. Най-голям е делът (49,6%) на държавната подкрепа за научните изследвания, насочени към „Общо развитие на знанието", като се включват основно научните изследвания, осъществявани от Българската академия на науките и университетите. Тази социално-икономическа цел е основна и за Европейския съюз през 2012 г., с дял от 51,6%.
През 2013 г., както и през предходната година, най-малък е делът на бюджетните средства за научни изследвания в областта на „Производство, съхранение, разпределение и използване на енергията" (0.2%, или 0,4 млн. лева).
Националното публично финансиране на научноизследователската и развойна дейност, координирана в ЕС на транснационално равнище, през 2013 г. възлиза на 5,3 млн. лв., или 2,7% от общите бюджетни разходи за НИРД. Този показател включва националния финансов принос за субекти от публичния сектор в ЕС, осъществяващи НИРД на транснационално равнище; националния финансов принос за общоевропейски публични програми за НИРД на транснационално равнище и за двустранни или многостранни публични програми за НИРД, установени между правителствата на държавите от ЕС.
Статистическото изследване на бюджетните разходи за научноизследователска и развойна дейност осигурява международно съпоставима информация за характеризиране на държавната подкрепа за развитие на НИРД, както и на приоритетните изследователски области, към които се насочват бюджетните средства за наука.
Показателят „Бюджетни разходи за научноизследователска и развойна дейност (НИРД)" измерва държавната подкрепа за развитие на НИРД, осъществявана както на територията на страната, така и извън нея. Това означава, че ежегодният членски внос в бюджета на международни научни организации, както и плащанията от бюджета, свързани с участието на Република България в двустранни и многостранни научноизследователски програми, също се третират като бюджетни разходи за НИРД.
Показателят „Бюджетни разходи за НИРД" включва текущите разходи и разходите за придобиване на дълготрайни материални активи, предназначени за НИРД.
В зависимост от крайната цел на научноизследователските проекти държавните бюджетни разходи за НИРД са разпределени по социално-икономически цели на базата на Номенклатурата за анализ и сравнение на научните програми и бюджети (NABS 2007).